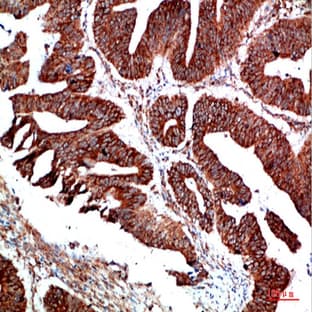
PTEN Polyclonal Antibody avatar

Abbkine Scientific Co.Ltd.
Our mission is to help make research possible by supplying scientists worldwide with the basic research tools necessary for advancing human and animal health. We would achieve these goals through a well-defined core strategy and a company culture that fosters integrity, openness, and collaboration, and rewards customer focus, innovation and ownership, thus offer global life science researchers with the highest quality products with an affordable pricing policy.
Abbkine started featured and exclusive products from protein detection tools and devoted to developing and providing the most innovative solutions for global customers covering all kinds of antibodies, biochemicals, proteins and assay kits. We're proud to provide below featured portfolio and will continue focusing on providing innovative, high quality and cost-effective life science research and diagnosis products.
• Full portfolio of epitope antibodies and internal control antibodies with custom conjugates;
• Full portfolio of phospho-specific and featured methylation-specific antibodies with small size;
• Top sale secondary antibodies with IFKine series for IF and IPkine for IP-WB analysis;
• Full portfolio of protein purification tools with high quality and competitive price;
• Top sale recombinant cytokines and growth factors;
• More Cell function analysis kits, ELISA kits and cell tracking reagents
Moreover, we have established technical service platforms for ELISA customized service, immunoassay service and protein expression and purification service, to provide one-stop experimental service with professional knowledge, facilities and attitude. Abbkine is aligned with, and responsive to, our customers’ ever-changing needs, making Abbkine a preferred discovery partner internationally.
Showing 24 of 2500 results
Product A-Z
Applications
ELISA, IF, IHC-F, WB
Hosts
Rabbit
Reactivities
Hum, Mouse, Rat
Applications
ELISA, IF, IHC-F, WB
Hosts
Rabbit
Reactivities
Hum, Mouse, Rat
Applications
IF, IHC-F
Hosts
Mouse
Reactivities
Hum, Mouse, Rat
Applications
ELISA, IF, IHC-F, WB
Hosts
Rabbit
Reactivities
Hum, Mouse, Rat
Applications
ELISA, IF, IHC-F, WB
Hosts
Rabbit
Reactivities
Hum, Mouse, Rat
Applications
ELISA, IF, IHC-F, WB
Hosts
Rabbit
Reactivities
Hum, Mouse, Rat
Applications
IF, IHC-F, WB
Hosts
Mouse
Reactivities
Hum, Mouse, Rat
Applications
IF, IHC-F
Hosts
Mouse
Reactivities
Hum
Applications
ELISA, IF, IHC-F, WB
Hosts
Rabbit
Reactivities
Hum, Mouse
Applications
ELISA, IF, IHC-F, WB
Hosts
Rabbit
Reactivities
Hum, Mouse, Rat
Applications
ELISA, IF, IHC-F, WB
Hosts
Rabbit
Reactivities
Hum, Mouse, Rat
Applications
ELISA, IF, IHC-F, WB
Hosts
Rabbit
Reactivities
Hum, Mouse, Rat
Applications
ELISA, IF, IHC-F, WB
Hosts
Rabbit
Reactivities
Hum, Mouse, Rat
Applications
ELISA, IF, IHC-F, WB
Hosts
Rabbit
Reactivities
Hum, Mouse, Rat
Applications
IF, IHC-F
Hosts
Mouse
Reactivities
Hum, Mouse, Rat
Applications
ELISA, IF, IHC-F, WB
Hosts
Rabbit
Reactivities
Hum, Mouse, Rat
Applications
ELISA, IF, IHC-F, WB
Hosts
Rabbit
Reactivities
Hum, Mouse, Rat
Applications
IF, IHC-F
Hosts
Mouse
Reactivities
Hum, Mouse, Rat
Applications
ELISA, IHC-F, WB
Hosts
Rabbit
Reactivities
Hum, Mouse, Rat
Applications
ELISA, IF, WB
Hosts
Rabbit
Reactivities
Hum, Mouse, Rat
Top suppliers
Agrisera AB
11 products
Biotrend
Biosensis
969 products
ABBIOTEC
3011 products
SDIX
1 products
Spring Bioscience
2291 products
Cell Signaling Technology
4976 products
Rockland Immunochemicals, Inc.
7592 products
Boster Immunoleader
1533 products
OriGene Technologies Inc.
5281 products
Maine Biotechnology Services
227 products
BD (Becton, Dickinson and Company)
1 products
ABNOVA CORPORATION
Randox Life Sciences
1502 products